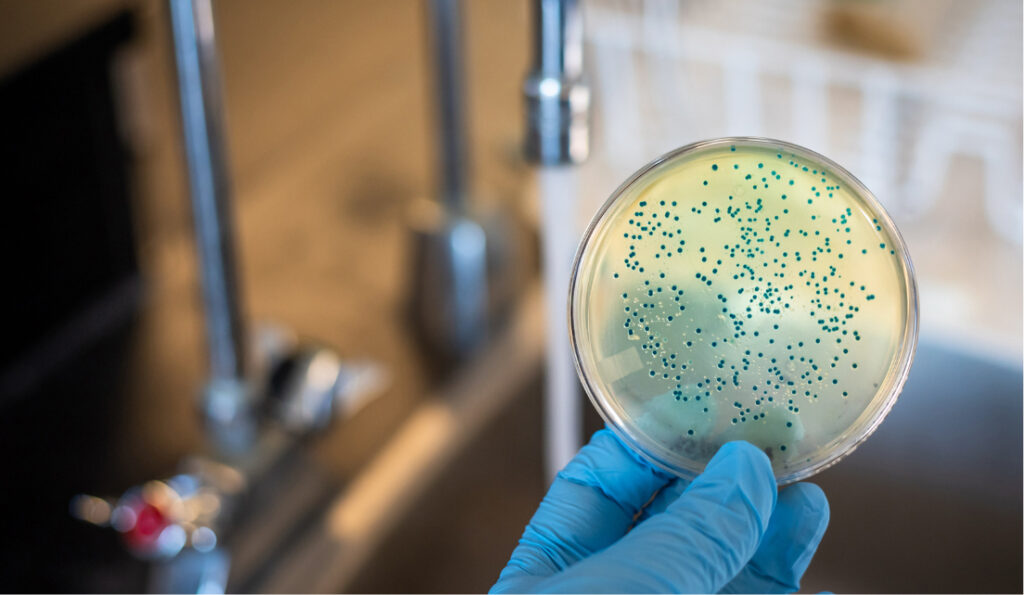

PROBLEM 
Bacteria In Your Water Isn’t Something To Mess With
PROBLEM 
Bacteria In Your Water Isn’t Something To Mess With
If your home uses well water, your water comes straight from the ground with no treatment along the way. That means bacteria like Coliform and E. Coli can show up at any time. And the tricky part is you cannot see, taste or smell it when bacteria is present.
Our UV systems eliminate 99.99% of bacteria in your water. There are no chemicals involved, nothing added to your water, and no changes to the taste. Just consistent, around-the-clock protection.
Even though you can test your water, bacteria levels can change quickly. With a UV system in place, your home is protected 24 hours a day, 365 days a year.
SOLUTION 
Simple, Safe Protection For Your Family
The most reliable way to deal with bacteria in well water is with an Ultraviolet (UV) Light Purification System. UV systems use high-frequency blue light to neutralize harmful microorganisms and limit their ability to reproduce. It is the same type of technology hospitals use to disinfect equipment and rooms.
Our UV systems eliminate 99.99% of bacteria in your water. There are no chemicals involved, nothing added to your water, and no changes to the taste. Just consistent, around-the-clock protection.
Even though you can test your water, bacteria levels can change quickly. With a UV system in place, your home is protected 24 hours a day, 365 days a year.
Maintenance Is Simple And Low Cost
We install the properly sized UV system for your home, and all it needs is a yearly lamp replacement and a quick cleaning of the quartz sleeve. The system has a built-in timer that alerts you when it is due.
Our office also sends reminders by text, phone call and postcard, so you never have to keep track of it. There are no contracts or maintenance agreements. We simply help you stay on top of it.
If you are not sure what is in your water, we can start with a free test and walk you through the right next steps.
BACTERIA TREATMENT PRODUCTS
Quality Systems Built To Protect Your Home
We only install systems we trust in our own homes. Our UV purification systems are safe, chemical-free and designed to run quietly and effectively all year long.
Ultraviolet (UV) Light Purification System
- Eliminates 99.99% of harmful bacteria
- Safe, chemical-free water treatment
- 24/7 protection for well water homes
- Low-maintenance yearly service
- Long-lasting, high-performance design
If you live on well water then bacteria presence is always a concern. This is the system we recommend every time.

FREE Water Testing
Removes The Guesswork
Bacteria can get into your well for all kinds of reasons, from heavy rain to small changes underground. The only way to know what is going on is to test your water.
We offer FREE water testing to confidently pinpoint your problem areas with your water supply. This allows you to rest easy that we have the right solution to deliver you clean and fresh tasting and smelling water for your home.
Contact the LOCAL and FAMILY-owned water Softener experts! Our products are designed specifically for the Lehigh Valley’s water.
FREE QUOTE
WE'RE HERE TO HELP
In need of a water softener installation or repair? At Lehigh Valley Water Systems, we specialize in providing high quality water testing and installs. Simply call us at 610-395-2005 or fill out the contact form below to get in touch with us!

